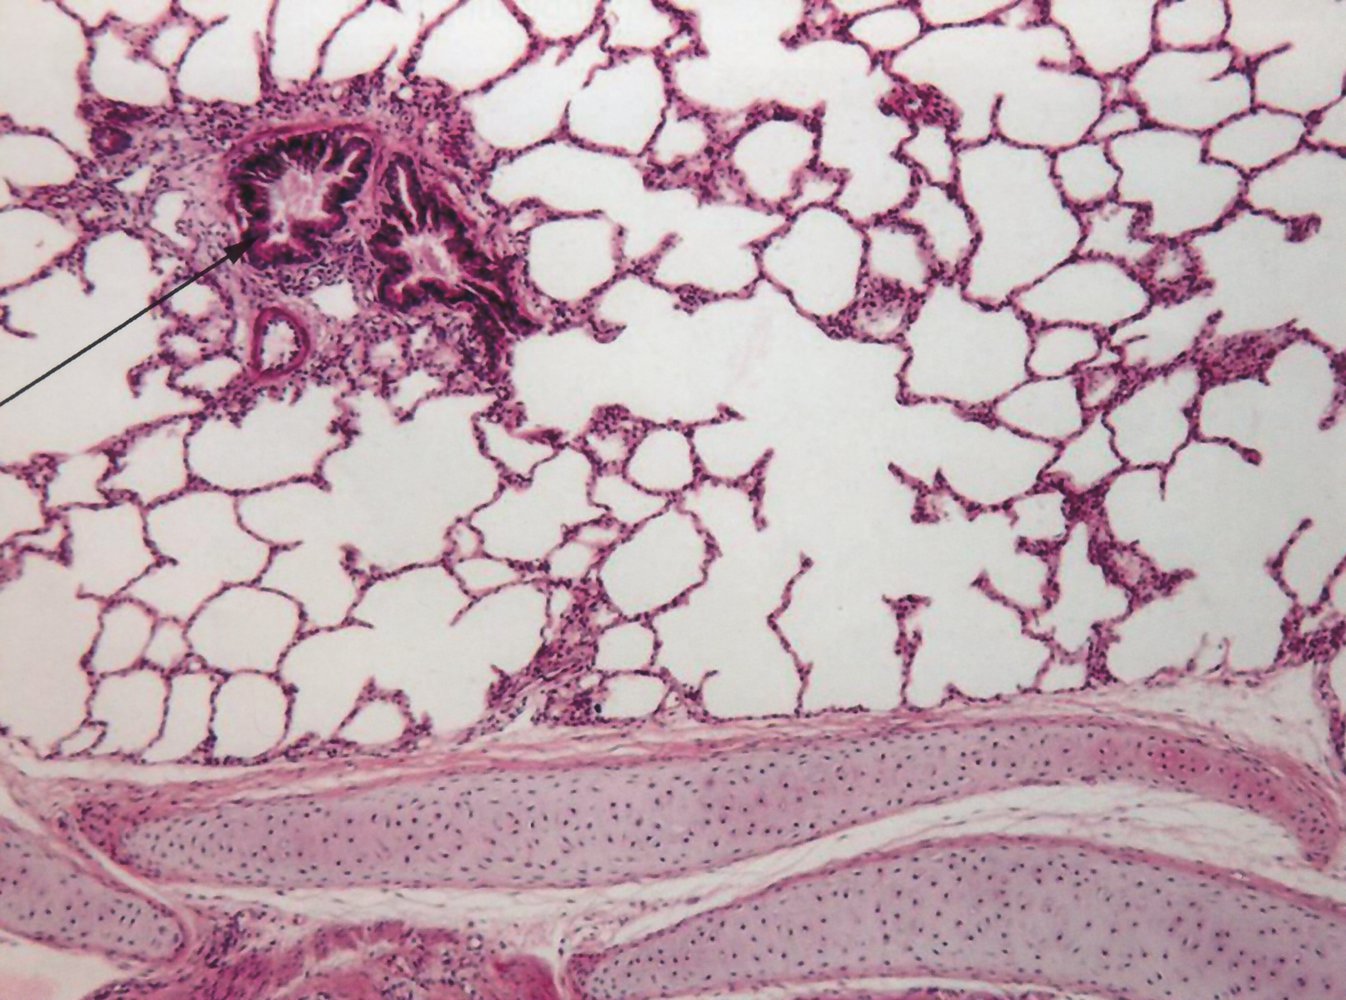

The respiratory system consists of a conducting zone (anatomic dead space; i.e., the airways of the mouth, nose, pharynx, larynx, trachea, bronchi, bronchioles, and terminal bronchioles) and a respiratory zone (lung parenchyma; i.e., respiratory bronchioles, alveolar ducts, alveolar sacs). The conducting zone is composed of nonrespiratory tissue and provides the passage for ventilation of the respiratory zone, where the O2 and CO2 exchange takes place. The respiratory system is furthermore divided into an upper tract (structures from the larynx upwards) and a lower tract (structures below the larynx). The entire respiratory tract down to the bronchioles is covered in ciliated epithelium, which provides immunologic protection by helping clear the airways of dust and microorganisms. Hyaline cartilage in the form of C-shaped rings (trachea) and plates (bronchi) provides structural protection and integrity. Gas exchange takes place in the alveoli of the lungs. The right lung consists of 3 lobes (upper, middle, lower), while the left lung consists of 2 lobes (upper, lower) and the lingula, a structure that is homologous to the middle lobe of the right lung. The left lung shares its space with the heart, which it accommodates in the cardiac notch. The development of the lungs begins in the embryonic period and continues until approximately 8 years of age.

Overview
Zones
- Conducting zone: large airways and small airways (intrapulmonary conducting system; nonrespiratory tissue)
- Respiratory zone: lung parenchyma (site of O2 and CO2 exchange)

Location
-
Upper respiratory tract
- Nasopharynx
- Larynx
-
Lower respiratory tract
- Trachea
- Bronchi, bronchioles
-
Lungs: located in the thoracic cavity (protected by the rib cage)
- Between the lungs: inferior mediastinum (including heart, large vessels, tracheal bifurcation, esophagus)
- Superior to the lungs: superior mediastinum
- Inferior to the lungs: diaphragm
- Anterior to the lungs: ribs
- Posterior to the lungs: vertebral column, ribs

Function
- Ventilation (distribution of air in the airway)
- Respiration: gas exchange (absorption of O2 into the blood and release of CO2 into the air)
- Immune defense (ciliary clearance, alveolar macrophages, goblet cells)
- For respiratory mechanics, see pulmonary function testing.
- For more information, see “Respiratory physiology.”
Intrapulmonary conducting system
Large airways
- Nose
-
Nasopharynx
- Most superior portion of the pharynx; connecting the nasal cavity to the oropharynx
- Contains the adenoids and eustachian tube openings
- Neighboring structures
- Anteriorly: the nasal choanae
- Posteriorly: clivus, prevertebral musculature covering C1–C2
- Laterally: pharyngeal opening of the eustachian tube, fossa of Rosenmuller, medial pterygoid plates, and superior pharyngeal constrictor muscles
- Larynx
-
Trachea
- Formed by a series of cartilages (15–20), joined together by annular ligaments.
- Bifurcates at the level of T4 into the left and the right main bronchus (tracheal carina)
- Neighboring structures
- Posterior: esophagus, descending aorta
- Anterior: thyroid, ascending aorta, brachiocephalic trunk, superior vena cava
-
Bronchi
- The right main (primary) bronchus divides into 3 lobar bronchi (secondary bronchi).
- The left main (primary) bronchus divides into 2 lobar bronchi (secondary bronchi).
- The lobar bronchi divide further into segmental bronchi (tertiary bronchi).



Small airways
- Bronchioles
- Terminal bronchioles
Function
- Conduction of air in and out of the respiratory tree
- Anatomic dead space (no gas exchange)
- Warms and humidifies air
- Mucociliary clearance: ciliated epithelium transports mucus, bacteria, and dust towards the throat, where it is either swallowed or expelled through the mouth
Respiratory zone
Lungs
-
Overview
- Paired organ of the respiratory system
- Located in the thoracic cavity
- Surrounded by the visceral pleura
- Hilum of the lung: the point of attachment of the lung to the lung root, which serves as the entry and exit site of the primary bronchi, pulmonary arteries and veins, bronchial arteries and veins, pulmonary nervous plexus, and lymphatics of each lung
-
Bronchopulmonary segments
- Segments of lung tissue that are supplied by a segmental bronchus and a segmental branch of the pulmonary artery.
- They are surrounded by a connective tissue septum (intersegmental septum), which encloses a branch of the pulmonary vein.
-
Lung parenchyma
- Respiratory bronchioles
- Alveolar ducts
- Alveolar sacs, which contain several pulmonary alveoli surrounded by capillaries
- Pulmonary acinus: a part of the airway distal to a terminal bronchiole; each acinus contains multiple respiratory bronchioles, alveolar ducts, alveolar sacs, and alveoli.
| Overview | ||
|---|---|---|
| Left lung | Right lung | |
| Lobes and bronchopulmonary segments |
|
|
| Bronchi |
|
|
| Notches |
|
|
Only the right lung has a middle lobe. It can be auscultated in the fourth to six intercostal space anteriorly at the midclavicular line.
The right main bronchus is wider, shorter, and more vertical than the left main bronchus so aspiration of foreign bodies and aspiration pneumonia are more likely in the right lung.
Each bronchopulmonary segment can be surgically removed without affecting the function of the others.
The Lingula is in the Left Lung.









Function
- Oxygen and carbon dioxide exchange across blood-air barrier
- Alveolar macrophages phagocytose fine dust particles (< 2 μm)
Vasculature
The lungs have a dual blood supply.
Pulmonary circulation
| Overview of pulmonary circulation | ||
|---|---|---|
| Vessels | Anatomy | Characteristics |
| Pulmonary trunk |
|
|
| Left pulmonary artery |
|
|
| Right pulmonary artery |
|
|
| Pulmonary veins |
|
|
Relationship of pulmonary arteries to the corresponding bronchi (Right: Anterior to the mainstem bronchus; Left: Superior to the mainstem bronchus): RALS.



Bronchial circulation
| Overview of bronchial circulation | ||
|---|---|---|
| Vessels | Anatomy | Characteristics |
| Bronchial arteries |
|
|
| Bronchial veins |
|
|
Lymphatics
- Lymphatic vessels drain the entire respiratory tree (lymphatic vessels are not present in the pulmonary alveoli)
- Intrapulmonary nodes → bronchopulmonary nodes → tracheobronchial nodes → paratracheal nodes → bronchomediastinal nodes and trunks → thoracic duct on the left and right lymphatic duct on the right
Innervation (pulmonary plexus)
- Branches accompany the blood vessels and bronchi into the lung.
- Parasympathetic fibers from the vagus nerve (M3 receptors) innervate smooth muscle and glands (bronchoconstriction, increase secretion)
- Sympathetic fibers (act on ß2-receptors): innervate blood vessels, smooth muscle, and glands (bronchodilation, vasoconstriction, decrease secretion)

Conducting zone
-
Nasopharynx
- Two main types of epithelium: stratified squamous epithelium and ciliated respiratory-type epithelium
- Lymphoid aggregates
- Goblet cells
- Seromucous glands
- Basal cells
-
Trachea and bronchi
- Pseudostratified ciliated columnar epithelium: important for mucociliary clearance
- Goblet cells
- Cartilage: C-shapedhyaline cartilage rings in the trachea and hyaline cartilage plates in the bronchi provide structural support.
- Annular ligaments of trachea: horizontal fibrous bands that join the tracheal cartilage rings together
- Smooth muscle
- Seromucous glands (secrete mucus)
- Basal cells
- Bronchioles: simple ciliated columnar epithelium; enclosed by smooth muscle
- Terminal bronchioles: simple ciliated cuboidal epithelium; smooth muscle

Respiratory zone [1]
Respiratory bronchioles
Respiratory bronchioles contain simple (non-ciliated) cuboidal and squamous epithelium and smooth muscle.
-
Club cells (formerly known as Clara cells)
- Maintain the integrity of the respiratory epithelium by secreting specialized immunomodulatory proteins, glycoproteins, and lipids.
- Cytochrome P450-dependent degradation of toxins
- Act as a reserve for ciliated cells to restore bronchiolar epithelium (stem cell properties) [2]
- Nonciliated, secretory, cuboidal cells located in the terminal and the respiratory bronchioles of the lung
-
Respiratory airway secretory cells (RAS cells) ; [3][4]
- Low cuboidal cells located in the distal airways and respiratory bronchioles
- Act as progenitor cells for type II pneumocytes
- Secrete proteins, glycoproteins, and lipids essential for the integrity of the respiratory epithelium
- Chronic exposure to tobacco (e.g., patients with COPD) alters gene expression and the differentiation pathway of type II pneumocytes.
Pulmonary alveoli
Pulmonary alveoli are separated from each other by the interalveolar septum with elastic fibers and capillaries. Interalveolar pores connect adjacent alveoli.
-
Type I pneumocytes: thin squamous cells that line the alveoli that allow for transcellular gas exchange
- Comprise 95% of the total alveolar area
- Connected to each other by tight junctions
- Form the blood-air barrier, together with the endothelial cells of the capillaries and the basement membrane between the two cells.
-
Type II pneumocytes: cuboidal alveolar cells
- Comprise 5% of the total alveolar area, but 60% of total number of cells
-
Surfactant formation: Type II pneumocytes contain lamellar bodies, which secrete surfactant (surface-activating lipoprotein complex).
- Surfactant is mainly composed of the phospholipids dipalmitoylphosphatidylcholine (DPPC or lecithin) and phosphatidylglycerol.
- It reduces alveolar surface tension and thereby prevents the alveoli from collapsing.
- Lung regeneration and repair: Type II pneumocytes can proliferate to replace type I or type II pneumocytes following lung damage.
-
Alveolar macrophages: phagocytose foreign materials and initiate the immune response by releasing cytokines
- Produce alveolar elastase, which is degraded by tissue inhibitors of metalloproteinases (TIMPs)
- Increased elastase activity is associated with the development of emphysema.
- Presence of hemosiderin-laden macrophages (or heart failure cells) may be a sign of pulmonary edema or alveolar hemorrhage (from pulmonary infarction, vasculitis, or aspiration of blood).
Pulmonary surfactant produced by type II pneumocytes reduces the surface tension of the thin layer of water that covers the pulmonary epithelium, thereby preventing alveolar collapse at end-expiration, increasing compliance, and reducing the work of breathing!
The presence on microscopy of hemosiderin-laden macrophages of lung tissue indicates alveolar hemorrhage or pulmonary edema.





Deposition and clearance of inhaled particles
Inhaled particles within the respiratory tree are cleared by different means depending on their size.
| Overview | ||
|---|---|---|
| Particle size | Deposit into | Clearance via |
| Small (< 3 μm) | Alveoli | Alveolar macrophages |
| Medium (3–10 μm) | Trachea and/or bronchi | Mucociliary clearance |
| Large (≥ 10 μm) | Nasal cavity | Nasal hair (vibrissae) |
The main function of the lung is the absorption of oxygen into the blood and the release of carbon dioxide into the air.
- For this purpose, the air must first reach the alveoli (see pulmonary function testing for respiratory mechanics).
- The distribution of air (ventilation) is adjusted to the perfusion of pulmonary vessels so that the gas exchange proceeds evenly.
- The respiratory center adjusts the breathing to the needs of the entire organism.
- For more information, see ”Respiratory physiology.”
| Overview of embryology [5] | ||
|---|---|---|
| Developmental stage | Description | Clinical significance |
| Embryonic period (weeks 4–7) |
|
|
| Pseudoglandular period (weeks 5–17) |
|
|
|
Canalicular period (weeks 16–25) |
|
|
|
Saccular period (weeks 26–birth) |
|
|
|
Alveolar period (week 36–8 years) |
|
|


- Pulmonary examination
- Pulmonary function testing
-
Embryonic abnormalities
- Congenital tracheoesophageal fistula
- Pulmonary hypoplasia
- Bronchogenic cysts
- Neonatal respiratory distress syndrome
- Surfactant deficiency
-
Tracheal conditions
- Tracheomalacia
- Tracheostomy
- Laryngotracheitis
- Obstructive lung diseases
- Restrictive lung diseases
- Interstitial lung disease
- Acute respiratory distress syndrome
- Pulmonary hypertension
- Pleural effusion
- Pneumothorax
- Atelectasis
- Pulmonary embolism
- Cystic fibrosis
- Pneumonia
- Tuberculosis
- Lung cancer
- Pneumonectomy
- Aging respiratory system